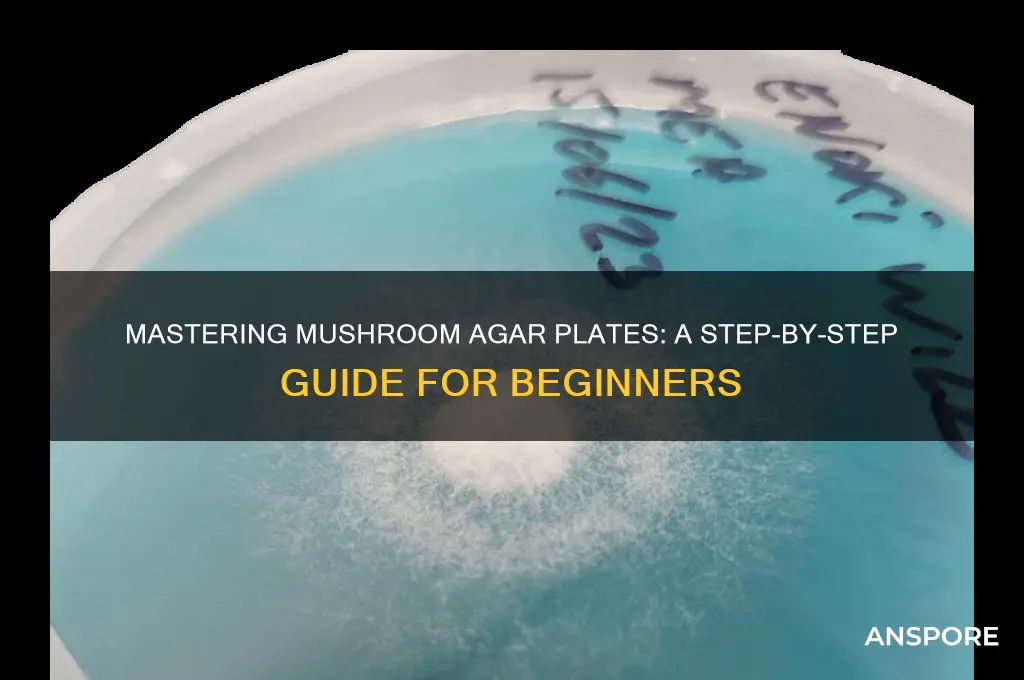
how to make mushroom agar plates

Making mushroom agar plates is a fundamental technique in mycology, essential for cultivating mushrooms from spores or mycelium in a sterile environment. The process begins with preparing a nutrient-rich agar medium, typically composed of water, agar powder, and a carbohydrate source like sugar or malt extract. This mixture is sterilized in an autoclave to eliminate contaminants, ensuring a clean substrate for fungal growth. Once cooled, the liquid agar is poured into Petri dishes under sterile conditions, often using a laminar flow hood to prevent airborne contamination. After solidifying, the plates are inoculated with mushroom spores or mycelium, then sealed and incubated at an optimal temperature to promote growth. This method allows for the isolation and propagation of specific mushroom strains, making it a cornerstone of both amateur and professional mushroom cultivation.
| Characteristics | Values |
|---|---|
| Purpose | To create a sterile medium for mushroom mycelium growth and isolation. |
| Base Material | Agar (derived from seaweed), typically 1.5-2% concentration in water. |
| Nutrient Source | Malt extract, dextrose, or other carbohydrate sources (e.g., potato dextrose). |
| Sterilization Method | Autoclaving at 121°C (250°F) for 15-30 minutes to kill contaminants. |
| pH Level | Adjusted to 5.5-6.0 using pH buffer solutions (e.g., HCl or NaOH). |
| Container Type | Petri dishes or glass jars with lids for sealing. |
| Inoculation Tool | Sterilized scalpel, inoculation loop, or syringe needle for transferring mycelium. |
| Incubation Conditions | 22-26°C (72-78°F), dark environment, for 7-14 days. |
| Contamination Prevention | Work in a sterile environment (e.g., still air box or laminar flow hood). |
| Storage | Refrigerate at 4°C (39°F) for up to 6 months; avoid freezing. |
| Common Additives | Antibiotics (e.g., streptomycin) or antifungals to prevent bacterial growth. |
| Cost | Low to moderate, depending on equipment and ingredients. |
| Difficulty Level | Intermediate; requires attention to sterility and technique. |
| Success Rate | High with proper sterilization and contamination control. |
| Applications | Mushroom cultivation, mycelium research, and species isolation. |
Explore related products
What You'll Learn
- Sterilize equipment: autoclave jars, lids, and tools to ensure a sterile environment for agar preparation
- Prepare agar mixture: combine agar powder, water, and nutrients, then sterilize the solution
- Inoculate with spores: introduce mushroom spores to the cooled, sterilized agar using sterile technique
- Seal and incubate: seal plates, store in a dark, warm place to promote mycelium growth
- Monitor for contamination: regularly check plates for mold or bacteria, discard if contaminated

Sterilize equipment: autoclave jars, lids, and tools to ensure a sterile environment for agar preparation
Sterilizing your equipment is a critical step in making mushroom agar plates, as it ensures a contamination-free environment for the agar and mushroom mycelium to thrive. The autoclave is the most reliable method for achieving this level of sterilization, as it uses high-pressure steam to kill all microorganisms, including spores. Begin by gathering all the necessary items: glass jars, lids, inoculation tools (such as scalpels or needles), and any other equipment that will come into contact with the agar or mycelium. Ensure these items are clean and free of debris before sterilization, as the autoclave process is designed to sterilize, not clean.
To prepare the equipment for autoclaving, start by placing the jars, lids, and tools into the autoclave chamber. It’s essential to arrange the items so that steam can circulate freely around them. For jars, leave the lids slightly ajar or use autoclave tape to secure them loosely, allowing steam to penetrate inside while preventing water from entering during the cycle. Wrap inoculation tools in aluminum foil or place them in a metal tray to keep them organized and prevent them from becoming hazards during handling post-sterilization. Double-check that all items are properly positioned to avoid damage to the autoclave or the equipment itself.
Once the equipment is loaded, set the autoclave to the appropriate cycle for sterilizing laboratory equipment, typically running at 121°C (250°F) for 15 to 30 minutes, depending on the volume of items being sterilized. This duration ensures that all microorganisms are eradicated. After the cycle completes, allow the autoclave to cool down naturally to avoid thermal shock to the glass jars. Do not open the autoclave prematurely, as this can compromise the sterilization process and introduce contaminants. Patience is key to maintaining the sterile environment you’re working to create.
After the autoclave has cooled, carefully remove the sterilized equipment using heat-resistant gloves or tongs, as the items will remain hot for some time. Place the jars, lids, and tools in a clean, sterile workspace, such as a laminar flow hood or a still-air box, to prevent contamination from the surrounding environment. Ensure the workspace is prepared beforehand with all necessary materials for agar preparation, as you’ll need to work quickly once the sterilized equipment is exposed. Keep the lids and jars closed until you’re ready to use them to maintain their sterile condition.
Finally, verify that the sterilization process was successful by checking the autoclave’s cycle log or using biological indicators if available. If any issues arise, such as an incomplete cycle or visible contamination, repeat the sterilization process before proceeding. Proper sterilization of jars, lids, and tools is non-negotiable in mushroom agar plate preparation, as even a single contaminant can ruin an entire batch. With this step completed, you’re ready to move on to preparing the agar solution in a sterile environment.
Brewing Maitake Mushroom Tea: Simple Steps for Earthy Wellness
You may want to see also

Prepare agar mixture: combine agar powder, water, and nutrients, then sterilize the solution
To prepare the agar mixture for mushroom agar plates, begin by gathering your ingredients: agar powder, distilled water, and nutrients such as light malt extract or sugar. The agar powder serves as the gelling agent, while the nutrients provide a food source for the mushroom mycelium. A common recipe includes 20-25 grams of agar powder per liter of water, along with 20-30 grams of light malt extract or sugar. Measure these ingredients precisely, as the correct ratios ensure a firm yet nutrient-rich agar substrate. Mix the agar powder and nutrients into the distilled water, stirring thoroughly to dissolve any clumps. Distilled water is preferred to avoid contaminants that may be present in tap water.
Once the ingredients are combined, transfer the mixture to a suitable container for sterilization. Erlenmeyer flasks or mason jars with loose lids are ideal, as they allow for proper ventilation during sterilization while minimizing the risk of contamination. Fill the container to about 75-80% of its capacity to prevent boiling over during the sterilization process. Secure the lid loosely to allow steam to escape, but ensure it is tight enough to prevent contaminants from entering after sterilization. Label the container with the date and contents for future reference.
Sterilization is a critical step to eliminate any bacteria, fungi, or other microorganisms that could compete with or harm the mushroom mycelium. The most common method is using an autoclave, which subjects the agar mixture to high-pressure steam at 121°C (250°F) for 30-45 minutes. If an autoclave is unavailable, a pressure cooker can be used as an alternative, maintaining 15 psi for 45 minutes. Ensure the sterilization process is complete before proceeding, as insufficient sterilization can lead to contamination. Allow the agar mixture to cool slightly in the autoclave or pressure cooker before handling to avoid burns.
After sterilization, let the agar mixture cool to a temperature safe for pouring, typically around 50-60°C (122-140°F). This can be done by allowing the container to sit at room temperature or by placing it in a warm water bath. Avoid cooling the mixture too quickly, as this can introduce contaminants or cause the agar to set prematurely. The agar solution should be clear and free of any particles, indicating successful sterilization and dissolution of ingredients. If the mixture appears cloudy or contains undissolved particles, it may need to be reheated or discarded.
Once the agar mixture is properly sterilized and cooled, it is ready for the next step in creating mushroom agar plates. Ensure your workspace is clean and sterile to maintain the integrity of the agar solution. Proper preparation of the agar mixture is foundational to successful mycology work, as it provides a clean and nutrient-rich environment for mushroom mycelium to grow and thrive.
Mastering Ground Mushroom Preparation: Simple Steps for Perfect Texture and Flavor
You may want to see also

Inoculate with spores: introduce mushroom spores to the cooled, sterilized agar using sterile technique
Inoculating your cooled and sterilized agar plates with mushroom spores is a critical step in the process of cultivating mushrooms. To begin, ensure your workspace is clean and free from contaminants. Sterile technique is paramount to prevent unwanted bacteria or mold from compromising your agar plates. Start by preparing your spore syringe, which contains the mushroom spores you intend to inoculate. Wipe the syringe’s plunger and needle with a 70% isopropyl alcohol solution to sterilize the surface, and allow it to dry completely before use. This minimizes the risk of introducing contaminants during the inoculation process.
Next, carefully remove the lid of your sterilized agar plate, ensuring it is only open for the shortest time possible to reduce exposure to airborne particles. Hold the plate in one hand and the spore syringe in the other. Insert the needle through the self-healing injection port of the plate or, if there is no port, gently pierce the sealing film. Inject 1-2 milliliters of spore solution into the agar, aiming to distribute the spores evenly without disturbing the agar’s surface too much. If using a spore print, lightly scrape spores onto the agar surface using a sterilized inoculation loop or scalpel, spreading them thinly and evenly.
After inoculation, promptly replace the lid of the agar plate to maintain sterility. Label the plate with the date, spore type, and any other relevant information for tracking purposes. Proper labeling is essential for managing multiple cultures and ensuring you can identify each plate later. Store the inoculated plate in a clean, dark environment at room temperature (around 70-75°F or 21-24°C) to encourage spore germination. Avoid placing the plate in direct sunlight or near heat sources, as this can hinder the growth process.
Maintaining sterile technique throughout the inoculation process cannot be overstated. Even minor lapses can lead to contamination, rendering your agar plates unusable. Always work with clean hands, wear gloves if possible, and use a laminar flow hood or a still-air box if available to create a sterile environment. If you notice any signs of contamination, such as unusual colors or odors, discard the plate immediately to prevent cross-contamination of other cultures.
Finally, monitor your inoculated agar plates regularly for signs of spore germination, which typically appears as white, thread-like mycelium growth within 7-14 days. Patience is key, as some species may take longer to colonize the agar. Once the mycelium has fully covered the plate, you can use it to expand your culture or transfer it to a bulk substrate for fruiting. Successful inoculation is the foundation of a thriving mushroom cultivation project, so take your time and prioritize precision and cleanliness at every step.
Cultivating Lion's Mane Mushroom: A Step-by-Step Guide to Growing at Home
You may want to see also
Explore related products

Seal and incubate: seal plates, store in a dark, warm place to promote mycelium growth
Once your mushroom agar plates have been inoculated with the spore or mycelium solution, the next critical step is to seal and incubate them properly to encourage healthy mycelium growth. Sealing the plates is essential to prevent contamination from airborne particles, bacteria, or mold. Use parafilm or micropore tape to tightly seal the edges of the Petri dishes. Parafilm is particularly effective as it creates an airtight seal and is flexible enough to accommodate the dish’s shape. Ensure there are no gaps or openings where contaminants can enter. If using tape, apply it carefully to avoid damaging the agar surface.
After sealing, label each plate with the date, mushroom species, and any other relevant details for tracking purposes. This step is crucial if you’re working with multiple strains or experiments. Once sealed and labeled, the plates are ready for incubation. The incubation environment should be warm and dark, as mycelium thrives in these conditions. Ideal temperatures typically range between 70°F to 75°F (21°C to 24°C), though this can vary slightly depending on the mushroom species. Avoid placing the plates in direct sunlight or near drafts, as fluctuations in temperature or light exposure can hinder growth.
A dark storage area, such as a closed cabinet or a dedicated incubation chamber, works best. If using a cabinet, ensure it’s clean and free from dust or other potential contaminants. For more controlled conditions, consider using an incubator with adjustable temperature settings. Place the plates in a way that allows for adequate air circulation, such as on a rack or tray, to prevent overheating or moisture buildup.
During incubation, monitor the plates periodically for signs of contamination or mycelium growth. Contamination may appear as discoloration, unusual textures, or foreign growths on the agar surface. If contamination is detected, isolate the affected plate immediately to prevent it from spreading to others. Healthy mycelium growth typically appears as white, thread-like structures spreading across the agar. Depending on the species and conditions, this can take anywhere from a few days to a couple of weeks.
Patience is key during the incubation phase, as rushing the process can lead to poor results. Avoid opening the plates unnecessarily, as this increases the risk of contamination. Once the mycelium has fully colonized the agar (usually when it covers 70-100% of the surface), the plates are ready for the next step, such as transferring the mycelium to grain spawn or bulk substrate. Proper sealing and incubation are fundamental to successful mushroom cultivation, ensuring a strong and healthy mycelium foundation for future growth.
Quick Microwave Grilled Mushrooms: Easy, Juicy, and Flavorful Recipe
You may want to see also

Monitor for contamination: regularly check plates for mold or bacteria, discard if contaminated
Monitoring for contamination is a critical step in the process of making mushroom agar plates, as it ensures the success and purity of your mushroom cultures. Contamination from mold, bacteria, or other microorganisms can quickly ruin your plates, wasting time, resources, and potentially spreading contaminants to other cultures. To effectively monitor for contamination, establish a routine of inspecting your agar plates at least once daily, preferably at the same time each day to maintain consistency. Look for any signs of discoloration, unusual growth, or textures that differ from the expected appearance of your mushroom mycelium. Early detection is key, as contaminants can spread rapidly once they take hold.
When inspecting your plates, pay close attention to the edges and the surface of the agar. Mold often appears as fuzzy, colorful growths in shades of green, black, or white, while bacterial contamination may look like slimy, wet patches or cloudy areas. Even small spots of contamination should be taken seriously, as they can indicate the presence of harmful microorganisms. Use a magnifying glass if necessary to spot subtle changes. Keep a record of your observations, noting the date and any suspicious findings, to track the health of your plates over time.
If you detect contamination, it is crucial to act swiftly to prevent it from spreading. Immediately isolate the contaminated plate by placing it in a sealed plastic bag to contain any spores or bacteria. Do not attempt to salvage the plate, as this risks cross-contaminating other cultures. Dispose of the contaminated plate properly, following local biohazard waste guidelines. Clean and sterilize the area where the plate was stored, including any tools or surfaces that may have come into contact with it, using a 10% bleach solution or another effective disinfectant.
To minimize the risk of future contamination, review your sterilization and plating techniques. Ensure that all equipment, including Petri dishes, inoculation loops, and workspaces, is thoroughly sterilized before use. Work in a clean, controlled environment, such as a still air box or laminar flow hood, to reduce the introduction of airborne contaminants. Additionally, use proper aseptic techniques, such as flaming your inoculation loop and avoiding unnecessary exposure of the agar to the environment. Regularly monitor humidity and temperature levels, as fluctuations can create conditions favorable for contamination.
Finally, consider implementing a quarantine system for new cultures or plates that have been exposed to potential contaminants. Keep these plates separate from your established cultures until you are confident they are free of contamination. This precautionary measure can help protect your primary cultures and save you from significant setbacks. By staying vigilant and proactive in monitoring for contamination, you can maintain the integrity of your mushroom agar plates and increase your chances of successful mycelium growth.
Crafting Creamy Mushroom Sauce: A Simple Scratch Recipe Guide
You may want to see also
Frequently asked questions
Mushroom agar plates are used to isolate and cultivate mushroom mycelium in a sterile environment, ensuring a pure culture free from contaminants for further cultivation or research.
You will need agar powder, mushroom spores or tissue, a pressure cooker or autoclave for sterilization, petri dishes, a stove or hotplate, and a sterile workspace or laminar flow hood.
Mix agar powder with water, pour it into petri dishes, and then sterilize both the agar solution and empty dishes in a pressure cooker or autoclave at 121°C (250°F) for 30–45 minutes to kill contaminants.
In a sterile environment (like a laminar flow hood), open the petri dish, introduce the mushroom spores or tissue using a sterile tool (e.g., inoculation loop), and quickly seal the dish to prevent contamination.











































